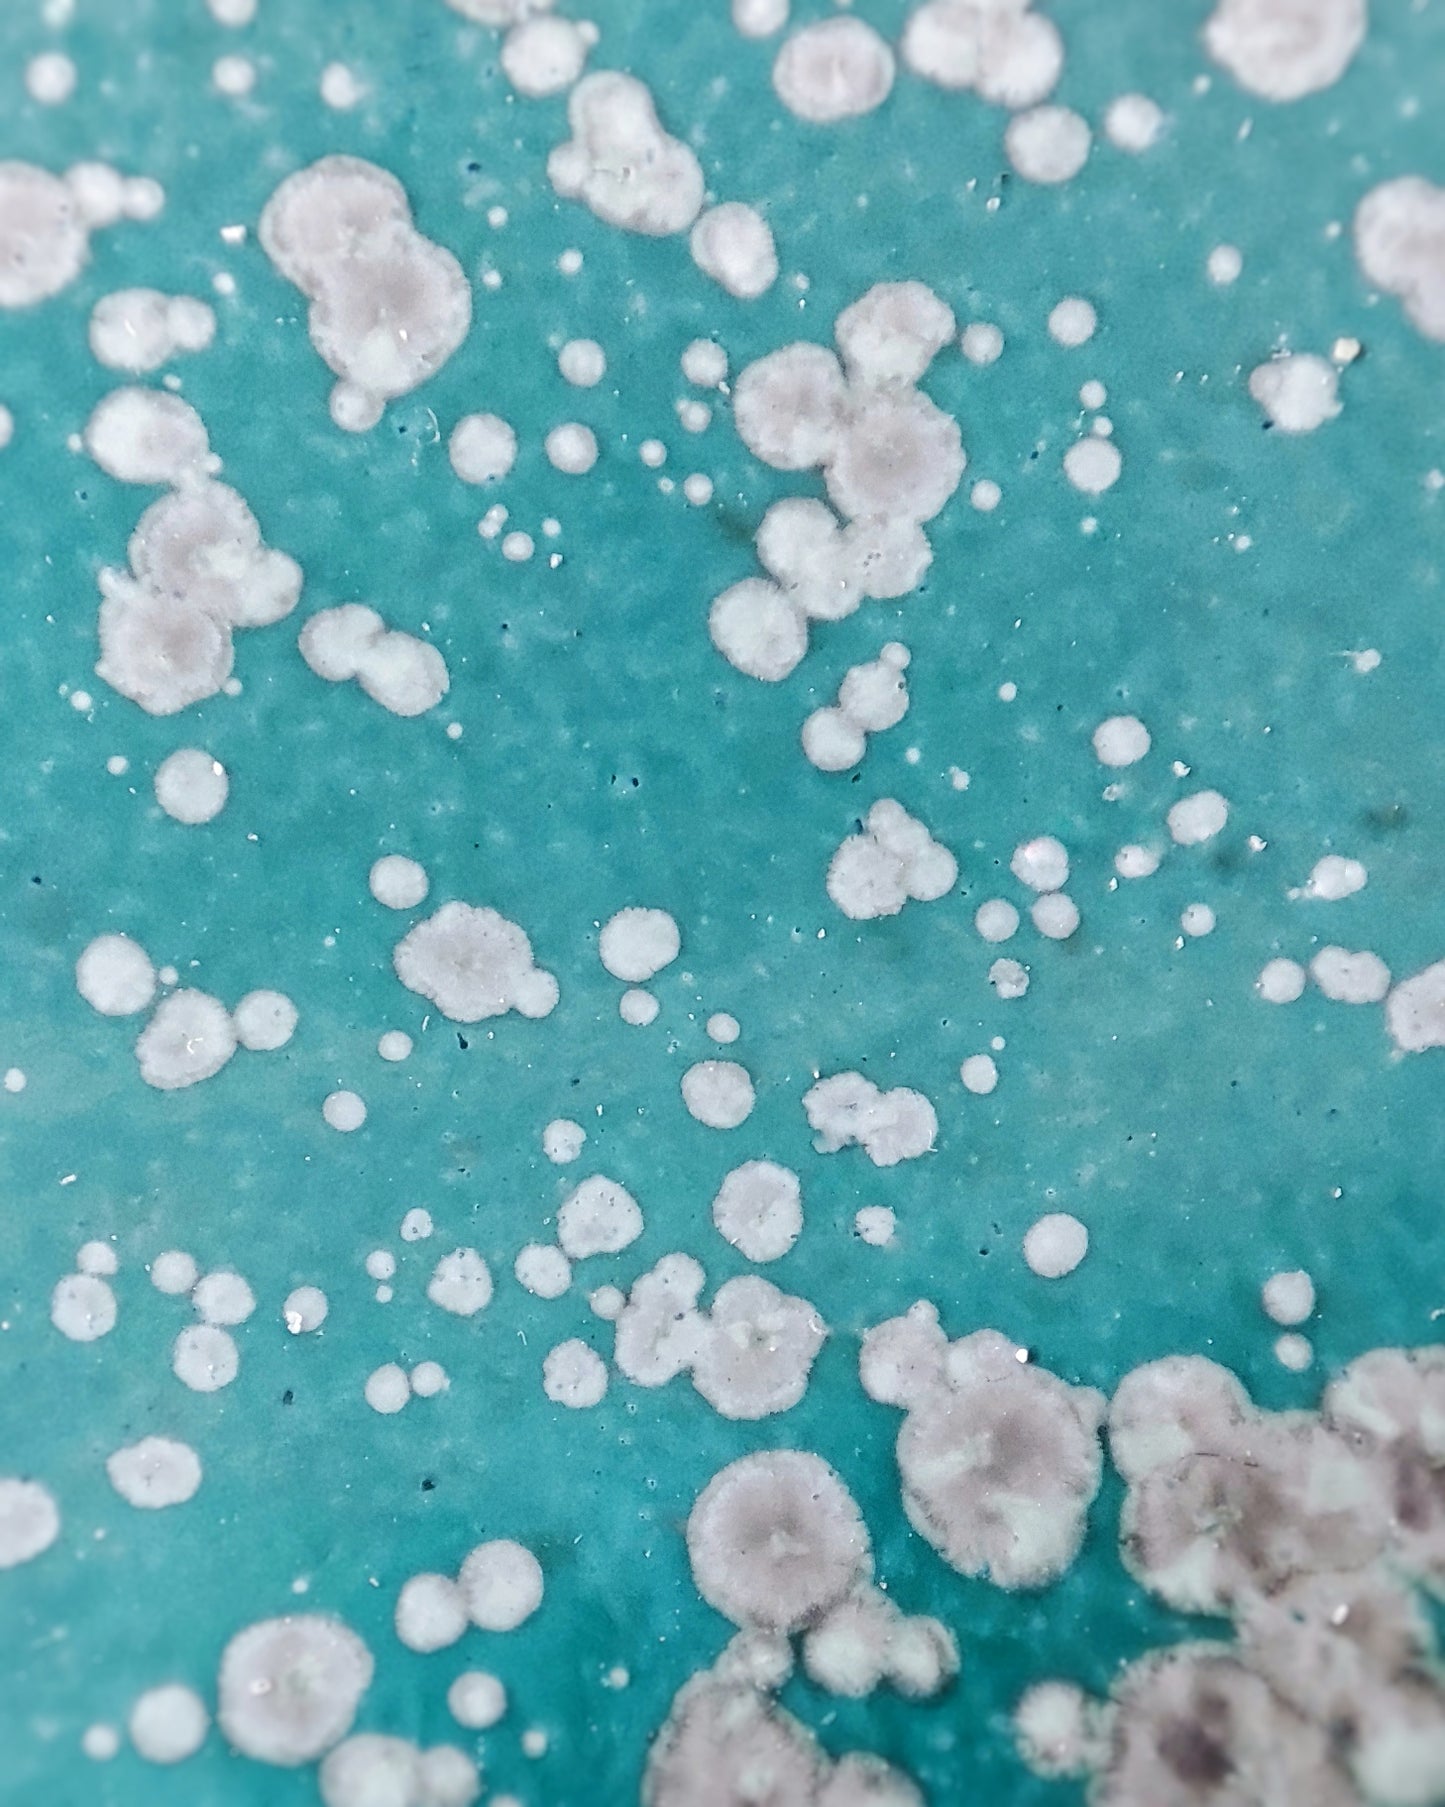
Piattini fondi (coppia), smalto Tundra

Piattini fondi (coppia), smalto Tundra
Piattini fondi (coppia), smalto Tundra
Dettagli del Prodotto
- Materiale: Gres beige
- Smalto: Tundra
- Cottura: Forno elettrico a 1240° C
- Altezza: 2 cm circa
- Diametro: 13 cm circa
Descrizione
Venduti in coppia, questi piattini dal profilo delicato e morbido si adattano perfettamente a qualsiasi tavola, rendendo ogni presentazione un momento di eleganza informale e dando un tocco di colore grazie al loro smalto Tundra. Ideali per servire antipasti, dolci o frutta.
Perfetti per:
- Servire antipasti, dolci o frutta
- Aggiungere un tocco di armonia alla tua tavola
- Fare un regalo speciale a qualcuno che apprezza l'artigianato artistico
Istruzioni per la cura:
Sebbene le nostre ceramiche siano resistenti alla lavastoviglie, raccomandiamo il lavaggio a mano per assicurarne la longevità e preservare la loro bellezza artigianale.
Un pezzo d'arte unico:
Ricorda, non siamo una fabbrica di ceramica ma un piccolo studio creativo. Ogni pezzo è fatto a mano, rendendolo unico - non ne troverai due identici su questo sito web o in qualsiasi altro luogo del pianeta. Questa unicità è ciò che rende queste ceramiche speciali, quindi ti preghiamo di maneggiarle con cura e tanto, tanto amore!
Per maggiori informazioni o richieste personalizzate, non esitare a contattarci.
Nota: Data la natura artigianale delle nostre ceramiche, si potrebbero riscontrare lievi variazioni di dimensioni, colore e texture. Queste piccole differenze contribuiscono ad aumentare il fascino unico di ogni pezzo.
Esaurito
Impossibile caricare la disponibilità di ritiro
Share